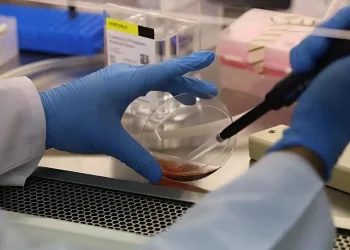
יש לך סוג דם O? את/ה כנראה יכול/ה להציל חיים - זה הרגע לפעול
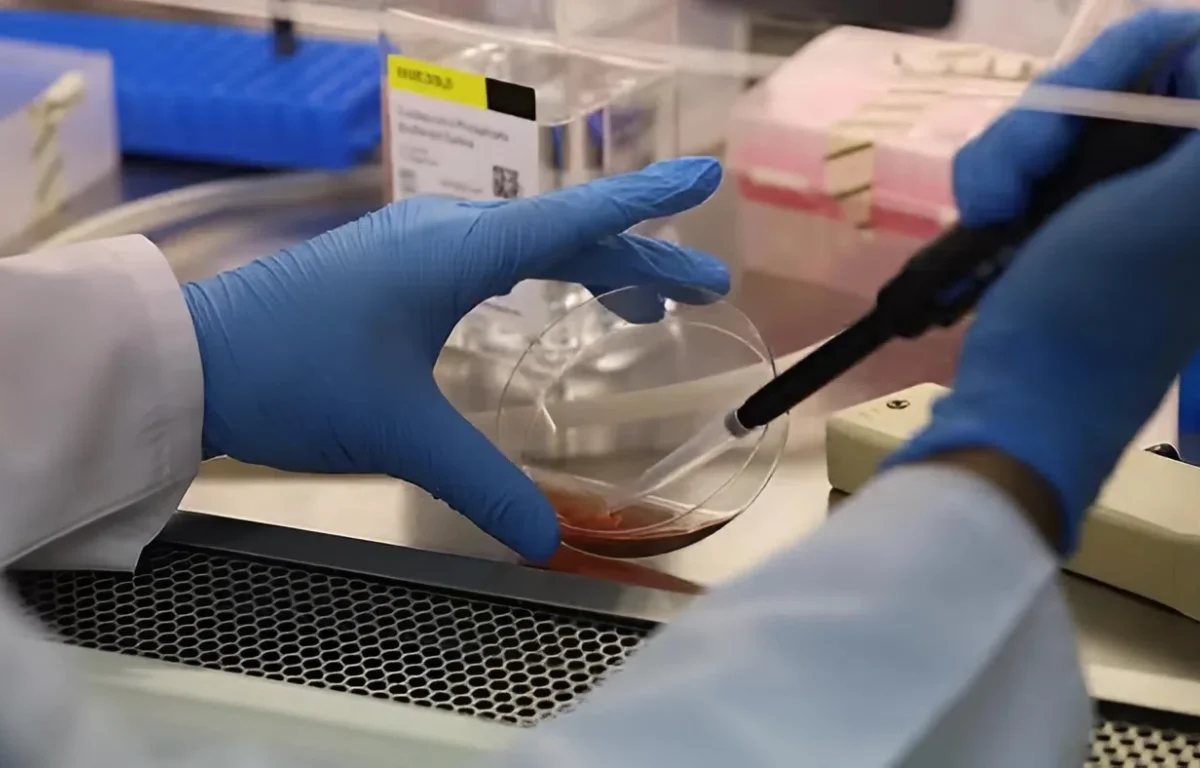
יש לך סוג דם O? את/ה כנראה יכול/ה להציל חיים - זה הרגע לפעול

בריאות
למרות שהציבור הישראלי יודע להתגייס היטב בשעת חירום, הפעם - תרומות הדם מדשדשות. הקריאות לעזרה לא מצליחות לחדור את רף הרעש הציבורי, והמערכת מתריעה: מאגר הדם, ובעיקר סוג O האוניברסלי - מתרוקן בקצב מהיר ומסוכן.
סוג דם O, שאינו נושא אנטיגנים על פני כדוריות הדם, הוא היחיד שניתן לכל חולה גם לפני קביעת סוג הדם המדויק - מצב קריטי במקרים של טראומה, פציעות קשות או טיפול מיידי. כל עוד סוג הדם של המטופל לא מזוהה, O הוא היחיד שיכול להציל חיים.
ד"ר רפאל סטרוגו, סמנכ"ל רפואה ושירותי הדם במד"א, מתאר את התמונה הקשה: "בזמן פיגועים או ירי טילים, אנחנו רואים התגייסות - אבל בשגרה הציבור מתעייף מהר. כדי לעמוד בצרכים - לא לחירום, לשגרה! - אנחנו זקוקים לפחות ל-1,200 תורמים ביום".
גם ד"ר אינה צורן, מנהלת אשפוז המטולוגי בקריה הרפואית רמב"ם, מדגישה: "במקרים של פציעות קשות, נותנים כבר בשטח מנת דם מלאה מסוג O. לכן חשוב שיהיה מלאי גדול. מדובר בדם שמציל חיים - ברגעים שבהם אין זמן".
בעוד שבימים הראשונים של הלחימה נרשמה ירידה כללית בפעילות האמבולטורית, בתי חולים כמו רמב"ם - המפעיל בית חולים תת-קרקעי - דווקא חוו עלייה משמעותית, בין היתר עקב קליטת חולים ממוסדות אחרים. "נכון להיום לא נאלצנו לבטל ניתוחים, אבל אם המחסור יימשך - זה יהיה הצעד הבא", מזהירה ד"ר לילך בונשטיין, מנהלת בנק הדם ברמב"ם.
לדבריה, במצב חירום נדרש מלאי גדול פי 4.5 מהמלאי הרגיל - משימה שבלתי אפשרית לעמוד בה בלי שיתוף פעולה נרחב מהציבור.
במד"א מודים: במצבים רבים - גם בשגרה - נמצאה המערכת "על הקצה". סטרוגו מספר על לילות ללא שינה, בהם עמדו בפני החלטות גורליות, בין אם לדחות ניתוח, ובין אם לשקול חלופה חלקית למנה מתאימה. "לא הגענו למצב שאין דם ליולדת מדממת - אבל היינו לא רחוקים משם".
הציבור לא תמיד מבין - דם אינו מוצר תעשייתי. "לא ניתן לייצר דם במעבדה. כל מנת דם מגיעה מתורם חי. זו רקמה - לא חומר. ובאין תורם - אין מענה", מבהירה ד"ר בונשטיין.
חולי סרטן המקבלים טיפולי מח עצם
מושתלי איברים
נשים בהיריון עם תת-סוגים רגישים
נפגעי טראומה שטרם זוהה סוג דמם
ודווקא משום שסוג O מתאים לכולם, הביקוש אליו עצום. אך גם סוגים אחרים - כמו AB - חיוניים: ממנו מפיקים את הפלזמה האוניברסלית, הנדרשת לחולים עם פרופיל נוגדנים נדיר.
מערך ההתרמות של מד"א עובד: עשרות צוותים, עשרות נקודות התרמה ביום - אך זה לא מספיק בלי התנדבות. "האמצעים קיימים, השינוע מוכן, גם הסיוע הבינלאומי מגובה - אבל בלי מי שייתן זרוע, אין מה להעביר", אומרים במד"א.
כיום, יש אף תוכנית חירום לייבוא מנות דם מחו"ל בשעת קיצון. אך נכון להיום - במשרד הבריאות ובמערכת הרפואית מקווים שלא יגיעו לשם.
סיכום וקריאה אחרונה:
אם יש לכם סוג דם O - זה הזמן לגשת.
אם אתם AB - ייתכן שאתם בעלי תרומה ייחודית.
ואם אתם סתם אזרחים שאכפת להם - תבואו.
כי כל טכנולוגיה, כל בינה מלאכותית, לא תחליף דבר אחד: דם אנושי.